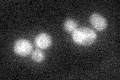
YHL048W
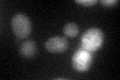
YHL048W
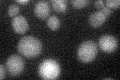
YHL048W

View description
Nuclear membrane protein, member of the DUP380 subfamily of conserved, often subtelomerically-encoded proteins; regulation suggests a potential role in the unfolded protein response
Localization:
Intensity:
Fold change:
Significance:
-
C’ GFP library in SD
ER25.8 -
N' NOP1pr-GFP in SD

vacuole43.2898 -
N' TEF2pr-mCherry in SD

below threshold6.11958 -
N' NATIVEpr-GFP in SD

below threshold16.1364 -
N' TEF2pr-VC and Cyto-VN in SD

#N/A0 -
C’ GFP library in SD+DTT
ER28.041.08No -
C’ GFP library in SD+H2O2

ER24.460.94No -
C’ GFP library in Starvation Media
ER28.621.1No -
C’ GFP library on the background of Pup2-DaMP

ER -
C’ GFP library on the background of CCT mutant

ER25.34730.982192No
